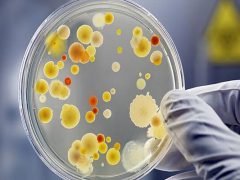

![]() 1
1幽门螺杆菌阳性+的意思是提示胃部有幽门螺杆菌感染了,幽门螺杆菌是外观呈螺旋形,它是与人类胃部多种疾病密切相关的一种细菌。 在1983 年由澳大利亚科学家首次从慢性活动性胃炎患者的胃钻膜组织中分离成功,是目前唯一可以在人胃中生存的微生物。 幽门螺杆菌阳性感染可以引起人类胃部多种疾病,目前探明的就有胃炎、胃部以及十二指肠溃疡以及胃私膜相关淋巴组织淋巴瘤等,更是胃...
针对疾病的治疗,挑选药品是十分关键的,药品分成中药和西药,应用不一样的用药治疗的实际效果也各不相同,中药材在许多疾病的治疗实际效果上全是较为好的,因而也让众多病人小伙伴们十分的关心。 幽门螺旋杆菌大伙儿应该都听说过的,下边和大家讨论一下幽门螺旋杆菌害怕的中药是什么? 一、幽门螺旋杆菌害怕的中药材 1、红毛丹 红毛丹对大伙儿而言应当是不会生疏的,它是一种营养成...
老中医秘方,最快杀死幽门螺旋杆菌的方法(必看贴) 不是所有感染幽门螺旋杆菌的人都必须要医治的,由于我国的幽门螺旋杆菌患病率十分高,感染人数高达全国总人数的80%左右! 大约有十几亿人都有感染幽门螺旋杆菌,假如感染幽门螺旋杆菌对人的危害都无限放大的话,那全国这么多人 都该怎么办呢,每天在消化内科治疗? 其实实际情况不是这样的,因此感染幽门螺旋杆菌也不用太紧张,...
幽门螺旋杆菌呈阳性怎么办?一定要医治,看完就懂了 通常在常规体检时候会有一项是幽门螺旋杆菌(通称HP)的检查,当結果呈阳性时,就会很担心,也有一部分还根本不知道什么是幽门螺旋杆菌。 对于幽门螺旋杆菌在网络上有各种各样的说法,幽门螺旋杆菌呈阳性会引起许多比较严重的问题,造成各种各样的病症,要马上清除细菌;也有说幽门螺旋杆菌的病症没有什么问题,吃点药就好了;还有...
![]() 2
2理论上而言,幽门螺旋杆菌是一种非常容易感染的病菌,一旦发觉,不管有没有临床表现,都应当积极主动除根。 但是,在我国人口数量大,要想筛选出全部的携带者不是实际的。因而,就算除根了也非常容易再度感染。 一旦复发,幽门螺旋杆菌对抗菌素的抗药性会提升,再次彻底清除的几率会变小、并发症的风险性会扩大。所以,现阶段临床医学权威专家对是不是必须消除幽门螺杆菌得到共识便是:...
![]() 3
3卫之幽能抑制清除幽门螺旋杆菌的真正原因 在网络上医药咨询仅作参考,需咨询专业问题请前往指定定点医疗机构咨询。 严格说来,卫之幽并不是清除幽门螺杆菌,专业名词称之为抵抗。杀死幽门螺杆菌并不是这么简单,由于在幽门螺杆菌的周边会产生“氨云”的保护层强度,使它不容易被胃液的干掉,一些抗菌素类药也没法透过“氨云”的保护层,杀掉幽门螺杆菌。 幽门螺杆菌不会轻易被完全杀死...
![]() 3
3卫之幽是能够消灭掉幽门螺旋杆菌的 通常治疗都是以抗生素为主导,辅加卫之幽益生菌粉、抑酸剂、铋剂,常用的抗生素是克拉霉素、阿莫西林胶囊、羟氨苄青霉素、青霉素等。市面上常用的益生菌有卫之幽益生菌粉,一般需要1~2周抗幽门螺旋杆菌传统四联治疗,再持续服用卫之幽益生菌粉一个月半之后大部分幽门螺旋杆菌患者均能痊愈。 针对消化不好,经常规治疗后效果不好的患...
HP食疗很好、上到老人,下到小孩,都可以适当的吃一些,卫之幽可以调理肠道菌群,让肠道菌群处在平衡的状态中,既可以缓解便秘也可以缓解腹泻,肠道通畅了,身体中的毒素堆积减少了,不但疾病会减少,皮肤也会变得更好。所以如果能经常适当的喝一些卫之幽益生菌,搭配卫益宁食疗丸,有助于身体健康。 幽门杆菌感染,胃经常不舒服,老是恶心,反胃,很难受。我也不喜欢吃药,所以买了这...
![]() 3
3后悔杀幽门螺杆菌,越杀越不好,为什么这么说呢? 我是患有胃病多年,并感染幽门螺杆菌的患者,我希望我的亲身经历,可以帮助更多有胃病或幽门螺杆菌无助和痛苦的朋友,使他们能够在少走弯路的途中早日康复。 如果您仍然依靠三联、四联疗法,输液,针灸等方法来杀灭幽门螺杆菌,那么,您的所有努力基本上都是徒劳的,可以说,是花更多的钱来延缓疾病的痛苦,所以说,千万不要盲目杀幽门...
![]() 3
3 胃幽门螺杆菌阳性是一种慢性胃炎疾病,是消化性溃疡的主要致病菌种,现在的研究表明,幽门螺杆菌感染与胃癌,和胃黏膜相关的淋巴瘤有密切关系,它是一种革兰氏阴性菌。 幽门螺杆菌经口进入胃后,借助鞭毛穿过粘液层,最终定居于胃窦黏膜上皮细胞的黏液层和表面,可导致胃窦细胞损害,还可以诱导自身产生免疫反应,最终导致胃粘膜损害,可引起胃炎,胃溃疡,...
 1
1 2
2 3
3 3
3 3
3 3
3